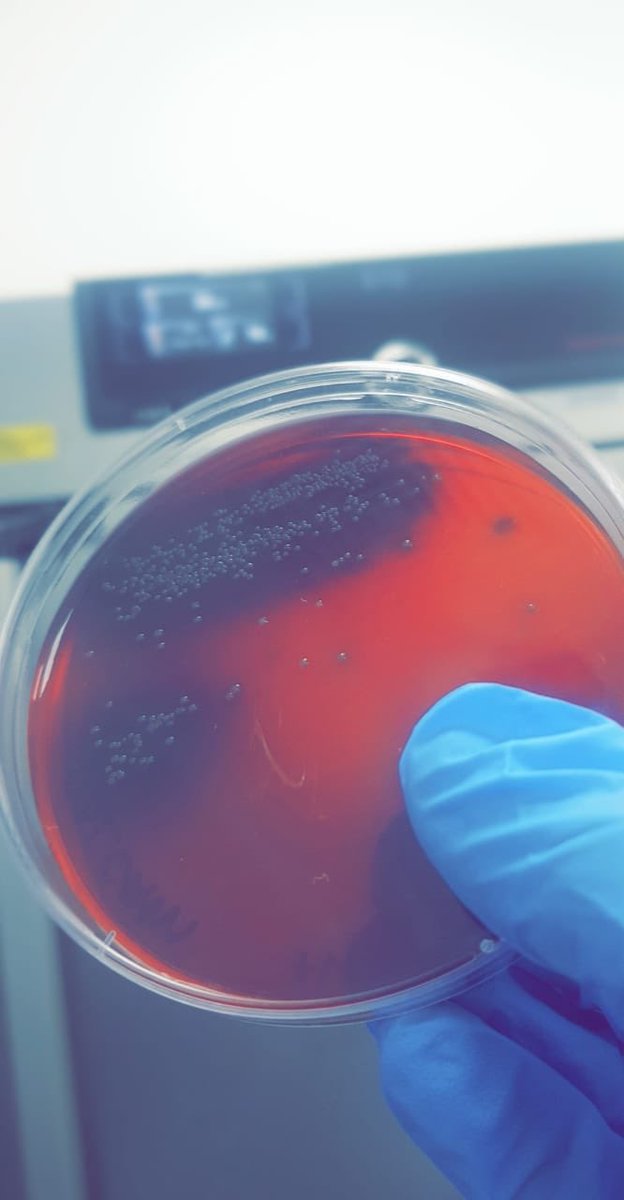
AMAN_ISolutions's tweet image. Listeria Spicies in palcum agar.
سلالات اللستيريا في اجار بالكوم

#AMANLAB #MICROBIALTESTING #FOODSAFETY

#microbialtesting search results
In this webinar, Dr. Madle Sirel, Product Manager at Symcel, will introduce the calScreener+ and walk through the key features that make it such a powerful platform for microbial detection. 👉 eu1.hubs.ly/H0pBk4K0 #MicrobialTesting #Microbiology #Biocalorimetry

New #MicrobialTesting Technology for #Cleanrooms Announced by @MOCONINC, @PMeasuringHQ hubs.ly/H020GMC0

Over the weekend we spoke at the 2018 @HarvardMSI Symposium discussing @FluidScreen applications in #microbialtesting & #cellseparation for #microbiome. Featured here are our wonderful team members, Nick, Alex, and Zach!

Day 1 was a success! We are ready for Day 2 of our Fundamentals of Medical Device Sterilization seminar and tours of our EO facility in Minneapolis and lab in Brooklyn Park, MN. #medicaldevice #microbialtesting


Idma Laboratories Ltd. Undertakes Instrumental, Microbiology and Chemical analysis of Fruit Juices & Energy Drinks #instrumentalanalysis #microbialtesting #biologicaltesting #chemicaltesting #beverage #industry #fruitjuice #energydrink #foodsafety #idmalaboratoriesltd #idmagroup

Top Drivers for #MicrobialTesting Market Size to Grow by $ 2.21 Billion During 2021-2025 technavio.com/talk-to-us?rep…

🔬 It's #TestingTuesday! 🌱 Yeast and mold are common, but identifying harmful types is crucial. Protect plants, cultivators, and consumers! Our tests cover plant products, edibles, and concentrates. Stay safe and informed! ✅🌿 #MicrobialTesting #SafetyFirst


Finished #microbialTesting over the weekend! Time to start w another set o test. #love_testing w @SpeedyBreedy

Why is DNA Testing important in #oilandgas? Microbial activity is one of the biggest contributors to #corrosion. Evolved DNA #microbialtesting aids in the connection between corrosion damage (MIC), such as pitting, and the presence of problematic microbes. bit.ly/microbialtesti…

#MicrobialTesting Market's 32% of the market’s growth will originate from #NorthAmerica. This market is concentrated & to get most of the opportunities, vendors should focus on growth prospects in the fast-growing segments. Know More: ow.ly/fGwa50Gnq2A Key Vendors list 👇

Join Us at Pharma Manufacturing World Summit 2025! 📍 Boston, MA | 🗓️ May 20–22, 2025 🔎 Visit us at Booth 15 to discover how our Growth Direct® System is transforming microbial quality control. #PMWS25 #PharmaManufacturing #MicrobialTesting #QualityControl #LifeSciences

Happening Now: European Microbiology Conference 🌍 📍 Vienna, Austria | 🗓️ May 20–22, 2025 Join us throughout the event to discover the latest innovations in microbial testing and quality control. #EuropeanMicrobiologyConference #MicrobialTesting #PharmaManufacturing

OSP opens NEW Technical Centre offering over 1,000 sq. ft. of pristine laboratory space, expanding technical testing services for the #oilandgas industry. Read more: bit.ly/OSPTechnicalCe… #microbialtesting #wellservices



Listeria Spicies in palcum agar. سلالات اللستيريا في اجار بالكوم #AMANLAB #MICROBIALTESTING #FOODSAFETY
Sam Santiago explains how MC-Media Pad® tests provide fast and accurate #microbialtesting results without sacrificing quality. Explore our portfolio for #MicrobialDetection and #Monitoring:... #TeamMerck bit.ly/3ng1wyZ

🔬Discover BioLabTests' comprehensive services: environmental, product & antimicrobial testing. Our passionate microbiologists support you from day one! eu1.hubs.ly/H08sP4T0 eu1.hubs.ly/H08sNR_0 #QualityControl #WorkspaceHygiene #MicrobialTesting
Oxygen Sensor-Based Respirometry and the Landscape of Microbial Testing Methods as Applicable to Food and Beverage Matrices mdpi.com/1424-8220/23/9… #microbialtesting #rapidmethods #foodquality #opticaloxygenrespirometry #oxygensensor #biosensor

In association with Andd Labs, We provide quality microbial testing services and reliable results. Let us support you breathe easier with our comprehensive microbial testing services. #microbiology #microbialtesting #consultancy #watermicrobiologyanalysis #foodmicrobiologytest

In this webinar, Dr. Madle Sirel, Product Manager at Symcel, will introduce the calScreener+ and walk through the key features that make it such a powerful platform for microbial detection. 👉 eu1.hubs.ly/H0pBk4K0 #MicrobialTesting #Microbiology #Biocalorimetry

One Device. Many Benefits. Detects NPK, pH, EC, organic carbon, microbes & more instantly! Email: [email protected] Call: +91 99250 27534 @SoilReport #microbialtesting #npkbalance #healthysoils #revenanosciences

🦠[Webinar] Microbial testing trends in food, cosmetics & pharma! 📅 July 23 (Wed) 3–4:30 PM JST 📍 Zoom 🎤 4 expert talks 💡 Rapid & traditional CFU methods 🔗 Register: yamato-net.co.jp/topics/detail/… #MicrobialTesting #RapidTesting #YamatoScientific #CFUcount
Don’t miss this opportunity to learn how precise reference standard quantification can accelerate microbial method validation and improve compliance. 🔗 Register Now: bit.ly/4kaNhH8 #MicrobialTesting #RapidMicrobialMethods #GMPCompliance #PharmaManufacturing #Biopharma

Webinar: Achieving Rapid Microbial Method Validation 📅 11 June 2025 | 🕒 3:00 PM BST / 10:00 AM EDT 🔗 Register Now: bit.ly/42OKpKo #MicrobialTesting #RapidMicrobialMethods #GMPCompliance #PharmaManufacturing #Biopharma #LifeSciences #Microbiology
Sterility testing is critical—but it doesn’t have to be complicated. Discover how Growth Direct® simplifies sterility validation, reduces manual handling, and accelerates time to results. Learn more: bit.ly/3ZaKd5I #SterilityTesting #MicrobialTesting #PharmaManufacturing

Webinar: Achieving Rapid Microbial Method Validation 📅 11 June 2025 | 🕒 3:00 PM BST / 10:00 AM EDT 🔗 Register Now: bit.ly/4iTBLPi #MicrobialTesting #RapidMicrobialMethods #GMPCompliance #PharmaManufacturing #Biopharma #LifeSciences #Microbiology

Happening Now: European Microbiology Conference 🌍 📍 Vienna, Austria | 🗓️ May 20–22, 2025 Join us throughout the event to discover the latest innovations in microbial testing and quality control. #EuropeanMicrobiologyConference #MicrobialTesting #PharmaManufacturing

Join Us at Pharma Manufacturing World Summit 2025! 📍 Boston, MA | 🗓️ May 20–22, 2025 🔎 Visit us at Booth 15 to discover how our Growth Direct® System is transforming microbial quality control. #PMWS25 #PharmaManufacturing #MicrobialTesting #QualityControl #LifeSciences

Webinar: Achieving Rapid Microbial Method Validation 📅 11 June 2025 | 🕒 3:00 PM BST / 10:00 AM EDT 🔗 Register Now: bit.ly/3GIrQ21 #MicrobialTesting #RapidMicrobialMethods #GMPCompliance #PharmaManufacturing #Biopharma #LifeSciences #Microbiolog

Both NA and PCA are essential in microbial testing, but did you know PCA may deliver slightly better results over repeated trials? Learn more about their uses, formulas, and best practices. 👉 Discover the details: bit.ly/3BaAFyV #MicrobialTesting #CultureMedia…
Is the Timing of the Microbial Release Testing of Drug Products Important? Read the article by Tony Cundell here - americanpharmaceuticalreview.com/Featured-Artic… #PharmaceuticalMicrobiology #GMPCompliance #MicrobialTesting #SterilityTesting #PharmaRegulations #QualityControl #PatientSafety

Want to restore your soil's microbial life and achieve long-term fertility? 🌱 Contact us at [email protected] to learn how our products can transform your farm. #RegenerativeFarming #SoilRegeneration #MicrobialTesting
In this webinar, Dr. Madle Sirel, Product Manager at Symcel, will introduce the calScreener+ and walk through the key features that make it such a powerful platform for microbial detection. 👉 eu1.hubs.ly/H0pBk4K0 #MicrobialTesting #Microbiology #Biocalorimetry

#microbialcontent #microbialtesting #hygenicfood #foodsafety #Idma #SophisticatedInstrumentationLaboratories #foodlaboratory #IdmaLaboratoriesLtd #analyticaltesting #qualitytesting #IdmaGroup #microlab #pharmalab #medicine #cosmetics #herbalife #ayurvedicmedicine #medicaldevices

New #MicrobialTesting Technology for #Cleanrooms Announced by @MOCONINC, @PMeasuringHQ hubs.ly/H020GMC0

#JASIS2023 New Technology Presentation ✨Hitachi High-Tech Corporation "Introduction of measurement example of Lumione BL3000, a rapid #microbial testing by the ATP method" #MicrobialTesting 🔶Sep. 4(Wed)-6(Fri), 2024@ Makuhari Messe #JASIS2024 program will be available in July!


Over the weekend we spoke at the 2018 @HarvardMSI Symposium discussing @FluidScreen applications in #microbialtesting & #cellseparation for #microbiome. Featured here are our wonderful team members, Nick, Alex, and Zach!

Two days left of the webinar series from QIAGEN - From field to food. Choose from time zone options and on-demand to suit your schedule. Details below 🦠🧀🍷 ow.ly/5oW450Tgsmx #fieldToFood #foodSafety #microbialtesting

#MicrobialTesting updates and new initiatives for #CannabisResearch: bit.ly/3wbVuUV #cannabisindustry #cannabis

Join Us at Pharma Manufacturing World Summit 2025! 📍 Boston, MA | 🗓️ May 20–22, 2025 🔎 Visit us at Booth 15 to discover how our Growth Direct® System is transforming microbial quality control. #PMWS25 #PharmaManufacturing #MicrobialTesting #QualityControl #LifeSciences

Happening Now: European Microbiology Conference 🌍 📍 Vienna, Austria | 🗓️ May 20–22, 2025 Join us throughout the event to discover the latest innovations in microbial testing and quality control. #EuropeanMicrobiologyConference #MicrobialTesting #PharmaManufacturing

Webinar: Achieving Rapid Microbial Method Validation 📅 11 June 2025 | 🕒 3:00 PM BST / 10:00 AM EDT 🔗 Register Now: bit.ly/4iTBLPi #MicrobialTesting #RapidMicrobialMethods #GMPCompliance #PharmaManufacturing #Biopharma #LifeSciences #Microbiology

Don't let cultures keep you down, MicroGenDX has your back. Our NGS technology offers faster and more precise detection and identification, leading to better treatment plans and outcomes. Go to loom.ly/FSV_dX0 to learn more! #MicroGenDX #PatientCare #MicrobialTesting

Webinar: Achieving Rapid Microbial Method Validation 📅 11 June 2025 | 🕒 3:00 PM BST / 10:00 AM EDT 🔗 Register Now: bit.ly/3GIrQ21 #MicrobialTesting #RapidMicrobialMethods #GMPCompliance #PharmaManufacturing #Biopharma #LifeSciences #Microbiolog

Mary Myers says hi from the @PathogenDX booth thx to our new lead sponsor #CannaEast2019 #microbialTesting

Day 1 was a success! We are ready for Day 2 of our Fundamentals of Medical Device Sterilization seminar and tours of our EO facility in Minneapolis and lab in Brooklyn Park, MN. #medicaldevice #microbialtesting


Idma Laboratories Ltd. Undertakes Instrumental, Microbiology and Chemical analysis of Fruit Juices & Energy Drinks #instrumentalanalysis #microbialtesting #biologicaltesting #chemicaltesting #beverage #industry #fruitjuice #energydrink #foodsafety #idmalaboratoriesltd #idmagroup

Why is DNA Testing important in #oilandgas? Microbial activity is one of the biggest contributors to #corrosion. Evolved DNA #microbialtesting aids in the connection between corrosion damage (MIC), such as pitting, and the presence of problematic microbes. bit.ly/microbialtesti…

Don’t miss this opportunity to learn how precise reference standard quantification can accelerate microbial method validation and improve compliance. 🔗 Register Now: bit.ly/4kaNhH8 #MicrobialTesting #RapidMicrobialMethods #GMPCompliance #PharmaManufacturing #Biopharma

Tailin takes advantage of technology & resources accumulated in the #Pharmaceutical industry for 30 years, and jointly builds an integrated service platform for #microbialtesting, validation, and identification with two leading companies. #lifesciences #tailinbioengineering




Something went wrong.
Something went wrong.
United States Trends
- 1. Clay Higgins 29.6K posts
- 2. Peggy 8,776 posts
- 3. Grisham 5,275 posts
- 4. Scotland 104K posts
- 5. Saudi 281K posts
- 6. Dominguez 3,412 posts
- 7. Switch 2 28K posts
- 8. Bellinger 3,057 posts
- 9. Cashman 1,473 posts
- 10. Dearborn 80.3K posts
- 11. Nicki 146K posts
- 12. Mary Bruce 8,788 posts
- 13. #LightningStrikes N/A
- 14. Khashoggi 67.3K posts
- 15. Gemini 3 57.5K posts
- 16. Jeffrey Epstein 363K posts
- 17. #drwfirstgoal N/A
- 18. Sedition 9,401 posts
- 19. Toyota 36.1K posts
- 20. Michigan State 8,837 posts






























